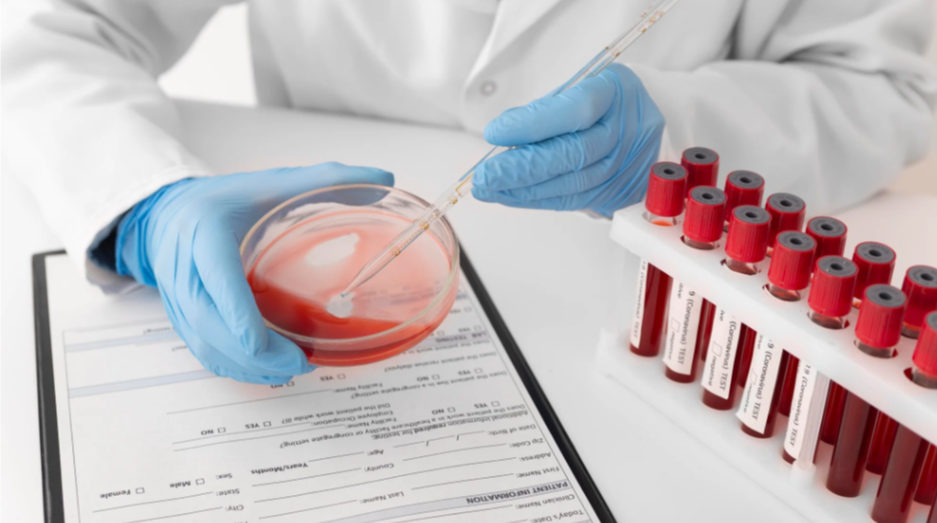

БЕСПЛАТНОЕ ОБСЛЕДОВАНИЕ ОРГАНИЗМА
23 показателя с лейкоцитарной формулой
23 показателя с лейкоцитарной формулой
ЗАПИСАТЬСЯ МОГУТ ЖИТЕЛИ ИЗ САНКТ- ПЕТЕРБУРГА В ВОЗРАСТЕ
ОТ 35 до 65 ЛЕТ
ОТ 35 до 65 ЛЕТ
ДО КОНЦА АКЦИИ:
0
Дней :
0 0
Часов :
0 0
Минут :
0 0
Секунд
Для чего это нужно?
Анализ крови является важным диагностическим методом, который помогает выявлять различные заболевания и оценивать общее состояние здоровья пациента. С его помощью можно определить уровень различных компонентов крови, таких как эритроциты, лейкоциты, тромбоциты, гемоглобин и другие биохимические показатели. Это позволяет диагностировать анемию, инфекции, воспалительные процессы, нарушения функции почек и печени, а также диабет и другие хронические заболевания. Анализ крови также используется для мониторинга эффективности лечения, оценки состояния иммунной системы и выявления дефицитов витаминов и минералов. Кроме того, регулярные исследования крови помогают врачу следить за изменениями в организме, что способствует раннему выявлению заболеваний и своевременному вмешательству.
Перечень исследований крови
-Лейкониты (WBC)
-Эритроциты (RBC)
-Гемоглобин (HGB)
-Гематокрит (НСТ)
-Средний объем эритроцита (MCV)
-Среднес содержание гемоглобина в эритроците (MCH)
-Средняя концентрация гемоглобина в эритроците (МСНС)
-Коэффициент вариации ширины распределения эритроцитов (RDW-CV)
-Стандартное отклонение ширины распределения эритроцитов (RDW-SD)
-Тромбоциты (PLT)
-Средний объем тромбоцита (MPV)
-Относительная ширина распределения тромбоцитов по объему (PDW)
-Тромбокрит (РСТ)
-Нейтрофилы (NEU)
-Нейтрофилы (NEU)
-Лимфоциты (LYM%)
-Лимфоциты (LYM#)
-Моноциты (MON)
-Эозинофилы (EO)
-Базофилы (ВА)
Перечень исследований крови
-Лейкониты (WBC)
-Эритроциты (RBC)
-Гемоглобин (HGB)
-Гематокрит (НСТ)
-Средний объем эритроцита (MCV)
-Среднес содержание гемоглобина в эритроците (MCH)
-Средняя концентрация гемоглобина в эритроците (МСНС)
-Коэффициент вариации ширины распределения эритроцитов (RDW-CV)
-Стандартное отклонение ширины распределения эритроцитов (RDW-SD)
-Тромбоциты (PLT)
-Средний объем тромбоцита (MPV)
-Относительная ширина распределения тромбоцитов по объему (PDW)
-Тромбокрит (РСТ)
-Нейтрофилы (NEU)
-Нейтрофилы (NEU)
-Лимфоциты (LYM%)
-Лимфоциты (LYM#)
-Моноциты (MON)
-Эозинофилы (EO)
-Базофилы (ВА)
ПОКАЗАНИЯ КОГДА НУЖНА ПОМОЩЬ ТЕРАПЕВТА
При ощущении смптомов перечисленных выше, рекомендовано обратиться к врачу
ЗАПИШИТЕСЬ НА АНАЛИЗ КРОВИ И КОНСУЛЬТАЦИЮ ТЕРАПЕВТА
ЗАПИСАТЬСЯ МОГУТ ЖИТЕЛИ ИЗ САНКТ- ПЕТЕРБУРГА В ВОЗРАСТЕ
ОТ 35 до 65 ЛЕТ
ОТ 35 до 65 ЛЕТ
ООО «КРАСИВЫЕ ЛЮДИ» Л041-01137-77/00626491
; ИНН 97293271529201529320; Москва, вн.тер.г. муниципальный округ Тропарево-Никулино, ул. Академика Анохина, д. 9, к. 1, помещение 5/1, офис 1
; ИНН 97293271529201529320; Москва, вн.тер.г. муниципальный округ Тропарево-Никулино, ул. Академика Анохина, д. 9, к. 1, помещение 5/1, офис 1



